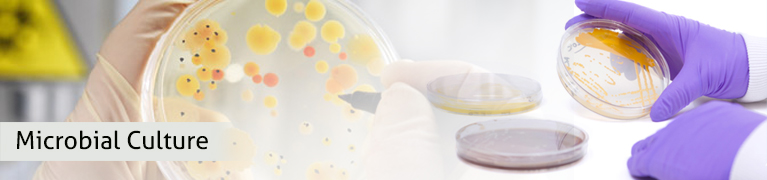
MICROBAIL CULTURE

MICROBIAL CULTURE
We are a recognized name and involved in offering an unmatched range of Composting MIcrobes. ACURO's microbial culture is a wonderful microbial product to resolve complex problems of sewage and solid waste treatment. Our multi-pronged sewage treatment solution refines the sewage and frees it from solid impurities to make it fit for industrial use thereby saving water required for composting. For sewage treatment, we use both anaerobic and aerobic methods.
FEATURES OF MICROBIAL CULTURE :
- It degrades variety of complex organic matter that natural microbes unable to degrade
- They multiply faster in the solid waste
- Also much effective in degrading fats, oil and grease
- Nature friendly
Acuro Organics Limited
Corporate office:
B-19, Sector-1, Noida-201301, UP, INDIA
TEL: +91-120-4888444 (100 lines)
Registered office:
DSM 446 & 447, DLF Corporate Tower,
Shivaji Marg, New Delhi-110015, INDIA






